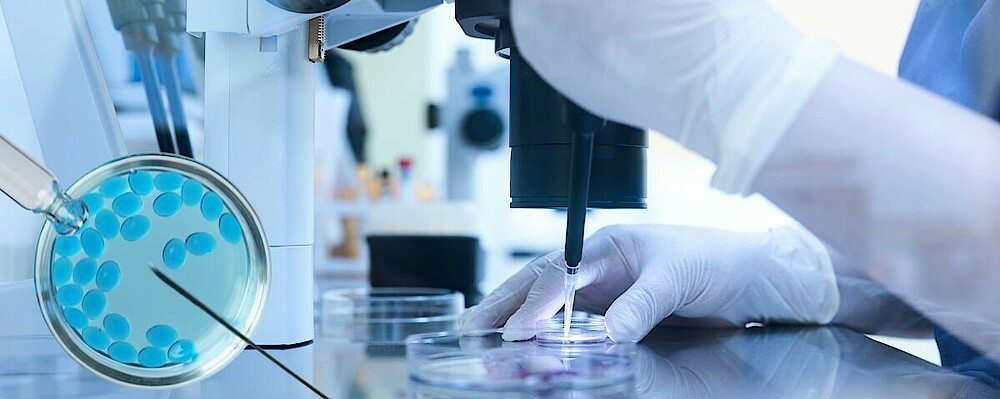

Reproduktionsmedizin
Reproduktionsmedizin beschäftigt sich mit Fortpflanzungsvorgängen. Der Schwerpunkt liegt in der Diagnostik von Unfruchtbarkeit und der Behandlung von Menschen mit unerfülltem Kinderwunsch.
Weiterführende Informationen
Allgemeines zur Reproduktionsmedizin
Der Wunsch nach einem Kind ist die natürlichste Sache der Welt und kann gleichzeitig zu einer massiven Belastung werden, wenn er sich (zunächst) nicht erfüllt. In dieser Situation ist es allzu verständlich, dass Paare die Möglichkeiten der Assistierten Reproduktionstechnologien in Anspruch nehmen. Dabei wird zunächst die Ursache für die ungewollte Kinderlosigkeit gesucht und ein individueller Behandlungsplan erstellt. Mehr zu Behandlungsmöglichkeiten bei unerfülltem Kinderwunsch finden Sie hier: https://www.familienplanung.de/kinderwunsch/behandlung/
Häufig entsteht der Eindruck durch die Reproduktionsmedizin sei alles machbar. Demgegenüber steht die Erfolgsrate der Kinderwunschbehandlungen, die sich mit zunehmendem Alter der Kinderwunschpaare verschlechtert. (Frauen im Alter von 30-34 Jahren haben eine Geburtenrate von 31,2% pro Embryotransfer, 41-44-jährige Frauen nur 8,4%) Quelle: https://www.deutsches-ivf-register.de/perch/resources/dir-jahrbuch-2023-sonderausgabe-fuer-paare.pdf
Zu bedenken sind auch die körperlichen und psychischen Auswirkungen einer Kinderwunschbehandlung. Eine psychosoziale Begleitung durch erfahrene Fachkräfte der Schwangerenberatungsstellen ist sehr empfehlenswert.
Die Möglichkeit der Befruchtung außerhalb des Mutterleibs hat eine Reihe von umstrittenen medizinischen Möglichkeiten mit sich gebracht. So zum Beispiel die genetische Untersuchung von Embryonen vor der Einsetzung in die Gebärmutter (Präimplantationsdiagnostik) oder Verfahren, die DNA- Bausteine im menschlichen Erbgut verändern können (Genome Editing "Gen- Schere"). Außerdem ist dadurch die Nutzung von Eizellen anderer Frauen (Eizellspende) oder das Austragen eines Kindes durch eine andere Frau (Leihmutterschaft) möglich geworden. Daraus ergeben sich ethische Spannungsfelder und es stellt sich die Frage nach rechtlichen und ethischen Grenzen.
In Deutschland ist sowohl die Eizellspende als auch die Leihmutterschaft verboten, um dem werdenden Kind keine gespaltene Mutterschaft zuzumuten. Derzeit prüft eine Expertenkommission im Auftrag der Bundesregierung, ob sich dies in Zukunft ändern soll.
Ethische Spannungsfelder
Die zwiespältigen Entwicklungen im Bereich der Fortpflanzungsmedizin bringen ethische Grundsatzfragen mit sich. So zum Beispiel:"Rechtfertigt der (unbedingt zu respektierende) Kinderwunsch den Zugriff auf Körper von Dritten?" oder "Gibt es ein Recht auf ein Kind?"
Kritisch zu betrachten sind auch:
- Verfolgung wirtschaftlicher Interessen auf Kosten von Wunscheltern
- Unrealistische Machbarkeitsversprechen mancher Kliniken
- Umgang mit „überzähligen“ Embryonen
- Gesundheitliche Risiken für Eizellspenderinnen und Leihmütter
- Auswirkungen von Eizellspenden und Leihmutterschaft auf das Kindeswohl
- Sozial hierarchische Gefälle verbunden mit Ausbeutung und Ausnutzen von prekären finanziellen Situationen
- Macht- Dynamiken auf dem globalen Markt der Reproduktionstechnologien
In keiner Weise geht es um Kritisieren oder Beurteilen individueller Entscheidungen von Wunscheltern.
Weiterführende Informationen
- https://www.eaf-bund.de/schwerpunkte/reproduktionsmedizin/positionspapier
- https://www.eaf-bund.de/sites/default/files/2020-07/Positionspapier_eaf_Reproduktionsmedizin.pdf
- https://www.familienplanung.de/kinderwunsch/
- https://www.informationsportal-kinderwunsch.de/
- https://shop.bzga.de/alle-kategorien/familienplanung/kinderwunsch/
- https://www.bmfsfj.de/bmfsfj/themen/familie/schwangerschaft-und-kinderwunsch/ungewollte-kinderlosigkeit/hilfe-und-unterstuetzung-bei-ungewollter-kinderlosigkeit-76012
- https://www.bmfsfj.de/resource/blob/95416/0277a83dc98150eae84dc086616a04a3/ungewollt-kinderlos-unterstuetzung-und-begleitung-fuer-betroffene-paare-flyer-data.pdf